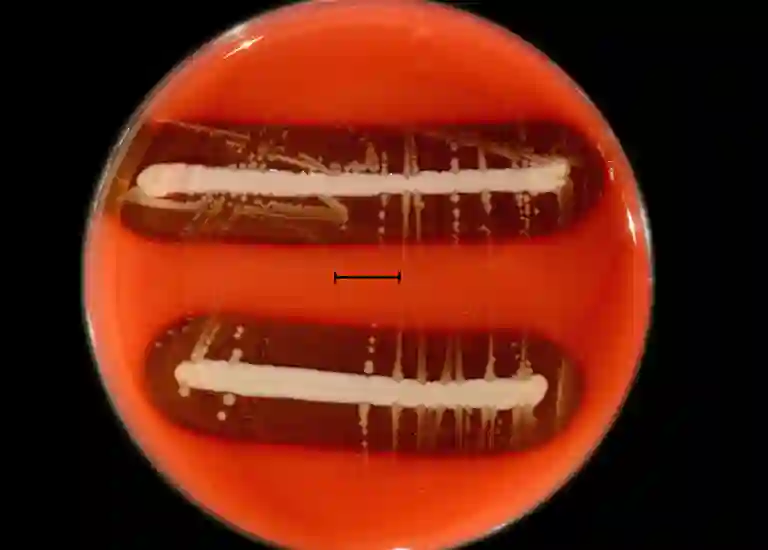

¿Qué es la coriza infecciosa aviar?
La coriza infecciosa aviar es una enfermedad bacteriana aguda que afecta principalmente a las aves de corral, causando significativas pérdidas económicas en la industria avícola. Esta enfermedad, causada por la bacteria Avibacterium paragallinarum, se caracteriza por síntomas respiratorios severos y puede afectar tanto a gallinas ponedoras como a aves de carne. El manejo adecuado de esta enfermedad es crucial para mantener la salud de la parvada y minimizar su impacto económico.
Etiología y Transmisión
La coriza infecciosa es causada por Avibacterium paragallinarum, una bacteria Gram negativa que coloniza las vías respiratorias superiores de las aves infectadas. Esta bacteria es altamente contagiosa y se transmite principalmente por contacto directo entre aves infectadas y sanas, así como a través de aerosoles y superficies contaminadas. Las aves portadoras asintomáticas pueden ser una fuente de infección constante en la parvada, lo que hace difícil erradicar la enfermedad sin un manejo estricto.
Signos Clínicos
Los signos de la coriza infecciosa aparecen rápidamente tras la exposición a la bacteria, generalmente entre 24 y 48 horas. Los signos clínicos incluyen:
- Secreción oculo-nasal: Comienza acuosa y se vuelve purulenta con el tiempo.
- Inflamación facial: Principalmente alrededor de los ojos y los senos paranasales, dando una apariencia hinchada a la cara de las aves.
- Estornudos y tos: Signos comunes debido a la irritación de las vías respiratorias.
- Dificultad respiratoria: En casos graves, la inflamación puede obstruir las vías respiratorias superiores.
- Disminución en la producción de huevos: Las gallinas ponedoras pueden reducir o cesar la puesta de huevos durante la enfermedad.

Diagnóstico
El diagnóstico de la coriza infecciosa se basa en una combinación de síntomas clínicos, historial de la parvada y pruebas de laboratorio. El aislamiento de Avibacterium paragallinarum a partir de exudados nasales o traqueales es el método definitivo para confirmar la enfermedad. Las pruebas serológicas, como ELISA, también pueden utilizarse para detectar anticuerpos contra la bacteria, especialmente en rebaños donde se sospecha la presencia de portadores asintomáticos.
¿Cómo prevenir la coriza?
La prevención de la coriza infecciosa se centra en la bioseguridad, la vacunación y el manejo adecuado de la parvada.
Bioseguridad: Implementar estrictas medidas de bioseguridad es fundamental para evitar la introducción de la bacteria en la parvada. Esto incluye el control del acceso a las granjas, la desinfección de equipos y vehículos, y la cuarentena de aves nuevas antes de introducirlas a la parvada.


Vacunación: Existen vacunas para aves disponibles que pueden ayudar a prevenir la coriza infecciosa. Estas vacunas son generalmente inactivadas y se administran en varias dosis a lo largo de la vida de las aves, comenzando a las 6-8 semanas de edad. Sin embargo, la vacunación debe complementarse con medidas de bioseguridad, ya que no previene completamente la infección, pero reduce la severidad de los síntomas y la diseminación de la enfermedad.
Manejo de la parvada: Mantener un ambiente limpio y libre de estrés es crucial para reducir la susceptibilidad de las aves a la enfermedad. Aves bien alimentadas y manejadas adecuadamente tienen un sistema inmunológico más fuerte, lo que puede ayudarlas a resistir mejor la infección.

Tratamiento
El tratamiento de la coriza infecciosa generalmente implica el uso de antibióticos para aves. Sin embargo, la resistencia bacteriana es un problema creciente, por lo que es esencial realizar un antibiograma para seleccionar el tratamiento más efectivo. Los antibióticos para aves comúnmente utilizados incluyen la estreptomicina, los macrólidos y las tetraciclinas. Además, es fundamental seguir el tratamiento completo y evitar el uso indiscriminado de antibióticos para prevenir la resistencia.
El tratamiento debe ser acompañado de un buen manejo de la parvada, que incluya la separación de aves enfermas y la mejora de las condiciones de alojamiento para reducir el estrés.
La coriza infecciosa aviar es una enfermedad que puede tener un impacto devastador en las explotaciones avícolas si no se maneja adecuadamente. La combinación de medidas preventivas como la vacunación y la bioseguridad, junto con un diagnóstico y tratamiento oportunos, es la mejor estrategia para controlar y prevenir la enfermedad. Los avicultores deben trabajar en estrecha colaboración con veterinarios para implementar estas estrategias y proteger la salud de sus parvadas.
Coribac es una vacuna de Lab Maver para prevenir la coriza infecciosa, brinda altos títulos de anticuerpos, dando así una máxima protección. De igual manera tenemos dos antibióticos para aves que ayudaran al control de la coriza en tus aves: Enrrox-10 y Macrotyl.

